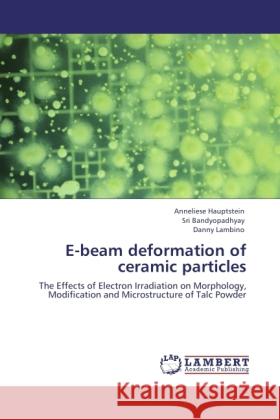
E-beam deformation of ceramic particles Hauptstein, Anneliese, Bandyopadhyay, Sri, Lambino, Danny 9783845418285 LAP Lambert Academic Publishing - książka

E-beam deformation of ceramic particles » książka
E-beam deformation of ceramic particles
ISBN-13: 9783845418285 / Angielski / Miękka / 292 str.
Electron irradiation may be a useful method for treating inorganic cosmetic powders such as talc for undesirable microorganisms if it can be established that no loss of quality or efficacy results as a consequence of the technique. A commercial electron accelerator was used to prepare bulk samples by exposure to electron irradiation under different conditions. A morphological characterisation of the control talc was carried out using microscopy techniques and focused on the particle size, shape and surface features of individual particles. Asperity dimensions vs. Roughness values were compared. Assessment of the bulk properties of the powders as a function of absorbed dose showed no serious impact on the quality or efficacy of the powder for cosmetic applications. The particle size and the level of dust expelled during impact were maintained. Changes to the surface chemistry of the irradiated powders were apparent from an increase in pH and water retention with increasing dose. Improvements to the fragrance retention occurred for both irradiated powders tested. Importantly a satisfactory microorganism level was achieved with the lowest absorbed dose level tested i.e. 5 kGy.